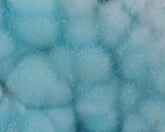
Blue Aragonite

-
Vendor:UnderGround Treasures
Dioptase with Chrysocolla
An aesthetic, cabinet-sized specimen featuring a colorful matrix hosting a perfectly centered dense cluster/ridge of lustrous, transparent to translucent, rich-green Dioptase crystals. Truly a beautiful piece with amazing color, luster, gemminess and balance! Size: test Location: test- $240.00
- $240.00
- Unit price
- per
-
Vendor:UnderGround Treasures
Aurichalcite with Calcite
A very aesthetic and colorful piece featuring a chocolate-brown Limonite matrix hosting a cluster of intergrown, transparent and lustrous Calcite rhombs heavily included by rich-teal, fibrous Aurichalcite across the top ridge. There are also small clusters and veins of radial, acicular Aurichalcite and Calcite...- $595.00
- $595.00
- Unit price
- per
-
Vendor:UnderGround Treasures
Brucite
Brucite is an uncommon mineral, up to now found only in a handful of deposits around the world and relegated to unimpressive shades of white to green. Thanks to new, recent finds in Pakistan, we now have Brucite with vibrant lemon-yellow crystals, with a...- $95.00
- $95.00
- Unit price
- per
-
Vendor:UnderGround Treasures
Brucite
Brucite is an uncommon mineral, up to now found only in a handful of deposits around the world and relegated to unimpressive shades of white to green. Thanks to new, recent finds in Pakistan, we now have Brucite with vibrant lemon-yellow crystals, with a...- $225.00
- $225.00
- Unit price
- per
-
Vendor:UnderGround Treasures
Aragonite
A large, lustrous radiating cluster of translucent red-brown Aragonite crystals. The crystals are considered pseudo-hexagonal, that is, they appear 6-sided but are actually three twinned crystals forming together. In excellent condition. Location: Tazouta, Sefrou Province, Fés-Boulemane, Morocco Size: 8 x 5 x 6.5 cm- $60.00
- $60.00
- Unit price
- per
-
Vendor:UnderGround Treasures
Aragonite
A large, lustrous radiating cluster of translucent red-brown Aragonite crystals. The crystals are considered pseudo-hexagonal, that is, they appear 6-sided but are actually three twinned crystals forming together. In excellent condition. Location: Tazouta, Sefrou Province, Fés-Boulemane, Morocco Size: 11 x 6.5 x 6 cm- $60.00
- $60.00
- Unit price
- per
-
Vendor:UnderGround Treasures
Aragonite
A large, lustrous radiating cluster of translucent red-brown Aragonite crystals. The crystals are considered pseudo-hexagonal, that is, they appear 6-sided but are actually three twinned crystals forming together. In excellent condition. Location: Tazouta, Sefrou Province, Fés-Boulemane, Morocco Size: 10 x 7 x 5.5 cm- $60.00
- $60.00
- Unit price
- per
-
Vendor:UnderGround Treasures
Celestine Geode
A large geode filled with gemmy, transparent blue Celestine crystals. The crystals are all in pristine condition and with no damage. I was able to pick through literally hundreds of Celestine Geodes in order to find a few that were exceptional including this one...- $250.00
- $250.00
- Unit price
- per
-
Vendor:UnderGround Treasures
Epidote
A lustrous dark-green cluster of Epidote crystals with striations and wedge-shaped terminations on a matrix of crystallized massive Epidote. Under lighting, the classic pistachio-green can be clearly seen. A very aesthetic specimen of Epidote in excellent condition. Location: Pampa Blanca, Castrovirreyna District, Huancavelica Department, Peru...- $135.00
- $135.00
- Unit price
- per
-
Vendor:UnderGround Treasures
Aegirine with Microcline
An uncommon specimen featuring intersecting crystals of burnt orange-colored Microcline hosting clusters of long and large, lustrous, deep-green Aegirine crystals along with thick and stubby crystals and dense clusters of thin crystals. A unique and collectable piece with great contrast, symmetry, and a wide...- $285.00
- $285.00
- Unit price
- per
-
Vendor:UnderGround Treasures
Chrysocolla with Malachite
This is a beautiful eye-catching piece of turquoise-blue Chrysocolla over botryoidal Malachite in a vug, with the layering nicely displayed on the edges. A very aesthetic specimen of Chrysocolla in excellent condition. Location: L'Etoile du Congo Mine, Lubumbashi, Katanga, DR Congo Size: 8.5 x 7 x...- $145.00
- $145.00
- Unit price
- per
-
Vendor:UnderGround Treasures
Aegirine with Microcline
An uncommon specimen featuring intersecting crystals of buff-colored Microcline hosting dense clusters of thin, lustrous, deep-green Aegirine crystals. A unique and collectable piece with great contrast and symmetry. In excellent condition. Location: Girardville, Québec, Canada Size: 5.5 x 3.5 x 4 cm- $50.00
- $50.00
- Unit price
- per
-
Vendor:UnderGround Treasures
Aegirine with Microcline
An uncommon specimen featuring intersecting crystals of buff-colored Microcline hosting dense clusters of thin, lustrous, deep-green Aegirine crystals. A unique and collectable piece with great contrast and symmetry. In excellent condition. Location: Girardville, Québec, Canada Size: 5 x 4 x 4.5 cm- $55.00
- $55.00
- Unit price
- per
-
Vendor:UnderGround Treasures
Celestine Geode
A large double geode filled with gemmy, transparent sky-blue Celestine crystals. The crystals are all in pristine condition, exceptionally large and with no damage. I was able to pick through literally hundreds of Celestine Geodes in order to find a few that were exceptional...- $290.00
- $290.00
- Unit price
- per
-
Vendor:UnderGround Treasures
Glendonite
This is a very unique specimen: A spherical cluster of brown Calcite crystals pseudomorphed after Ikaite. The Calcite chemically replaced the mineral Ikaite while retaining the crystal shape of the original Ikaite. Although not an official name, this particular specimen/pseudomorph is referred to as...- $55.00
- $55.00
- Unit price
- per
-
Vendor:UnderGround Treasures
Glendonite
This is a very unique specimen: A spherical cluster of brown Calcite crystals pseudomorphed after Ikaite. The Calcite chemically replaced the mineral Ikaite while retaining the crystal shape of the original Ikaite. Although not an official name, this particular specimen/pseudomorph is referred to as...- $55.00
- $55.00
- Unit price
- per
-
Vendor:UnderGround Treasures
Glendonite
This is a very unique specimen: An elongated cluster of brown Calcite crystals pseudomorphed after Ikaite. The Calcite chemically replaced the mineral Ikaite while retaining the crystal shape of the original Ikaite. Although not an official name, this particular specimen/pseudomorph is referred to as...- $65.00
- $65.00
- Unit price
- per
-
Vendor:UnderGround Treasures
Creedite
Two spherical groupings of radiating, transparent to translucent orange Creedite crystals on contrasting matrix. The Creedite crystals are gem-like in their luster and transparency. A beautiful piece in excellent condition. Location: Navidad Mine, Abasolo, Municipio de Rodeo, Durango, Mexico Size: 6 x 3.5 x 5 cm...- $95.00
- $95.00
- Unit price
- per
-
Vendor:UnderGround Treasures
Cassiterite
This aesthetic piece features a matrix of clear, crystalline Quartz hosting two black, lustrous, mirror-like Cassiterite crystals. The contrast is amazing! The large, focal Cassiterite crystal is striking, especially against the Quartz backdrop. In excellent condition. Location: Viloco Mine, Loayza Province, La Paz Department, Bolivia...- $170.00
- $170.00
- Unit price
- per
-
Vendor:UnderGround Treasures
Cassiterite
This cabinet-sized piece features a dense coating of black, lustrous, sharp Cassiterite crystals with minor clear Quartz on matrix from the famous Viloco Mine in Bolivia. The Cassiterite crystals are exceptionally large, very sharp and mirror-like and contrast nicely with the Quartz crystals. The...- $325.00
- $325.00
- Unit price
- per
-
Vendor:UnderGround Treasures
Cassiterite
This cabinet-sized piece features numerous black, lustrous, sharp Cassiterite crystals on a matrix of clear, microcrystalline Quartz from the famous Viloco Mine in Bolivia. The Cassiterite crystals are exceptionally large, very sharp and mirror-like and contrast nicely with the microcrystalline Quartz. The crystal edges...- $220.00
- $220.00
- Unit price
- per
-
Vendor:UnderGround Treasures
Blue-Green Aragonite
Aragonite comes in many forms and colors, one of the most common being the radiating clusters of translucent red-brown pseudo-hexagonal clusters. What makes this particular piece so unique is for one; its wheel shaped formation of parallel pseudo-hexagonal crystals. But by far, the most...- $195.00
- $195.00
- Unit price
- per
-
Vendor:UnderGround Treasures
Aragonite Stalactite
A large stalactitic formation of translucent, lustrous white, cave Aragonite. A very aesthetic piece with countless delicate branching crystals throughout. Great luster, crystal formation and size. In excellent condition. Location: Chihuahua, Mexico Size: 13.5 x 9 x 12.5 cm- $140.00
- $140.00
- Unit price
- per
-
Vendor:UnderGround Treasures
Astrophyllite
This large piece hosts numerous sprays of radiating, bronze-colored Astrophyllite crystals with metallic-like luster on matrix. Great symmetry and luster. Unique and aesthetic piece in excellent condition. Location: Eveslogchorr Mt., Khibiny Massif, Kola Peninsula, Russia Size: 9.5 x 3.7 x 8.5 cm- $165.00
- $165.00
- Unit price
- per
-
Vendor:UnderGround Treasures
Cassiterite
Black, lustrous, sharp Cassiterite crystals on colorless to white Quartz matrix from the famous Viloco Mine in Bolivia. The Cassiterite crystals are large, very sharp and mirror-like and contrast amazingly with the white Quartz matrix. A very aesthetic piece in excellent condition. Location: Viloco Mine,...- $195.00
- $195.00
- Unit price
- per
-
Vendor:UnderGround Treasures
Cassiterite
This cabinet sized piece features a dense coating of black, lustrous, sharp Cassiterite crystals on a rust-colored matrix from the famous Viloco Mine in Bolivia. The Cassiterite crystals are large, very sharp and mirror-like and contrast amazingly with the matrix. A very aesthetic piece...- $95.00
- $95.00
- Unit price
- per
-
Vendor:UnderGround Treasures
Astrophyllite
A large piece with dense coverage of golden-brown Astrophyllite blades on a contrasting matrix of white Quartzite. The size, contrast and metallic luster make for a unique and aesthetic specimen. In excellent condition. Location: Eveslogchorr Mt., Khibiny Massif, Murmansk Oblast, Russia Size: 6 x 3 x...- $90.00
- $90.00
- Unit price
- per
-
Vendor:UnderGround Treasures
Astrophyllite
A large piece with dense coverage of golden-brown Astrophyllite blades on a contrasting matrix of white Quartzite. The size, contrast and metallic luster make for a unique and aesthetic specimen. In excellent condition. Location: Eveslogchorr Mt., Khibiny Massif, Murmansk Oblast, Russia Size: 8 x 4 x...- $110.00
- $110.00
- Unit price
- per
-
Vendor:UnderGround Treasures
Blue Aragonite
An extremely aesthetic specimen of botryoidal sky-blue Aragonite with needle-like (acicular) crystals throughout on dark-brown matrix. The unique sky-blue color is a result of copper inclusions, creating a unique, natural (no artificial dyes) and beautiful color. In excellent condition. Location: Yunan Province, China Size: 9.5 x...- $220.00
- $220.00
- Unit price
- per
-
Vendor:UnderGround Treasures
Blue Aragonite
A large and extremely aesthetic specimen of sky-blue Aragonite featuring numerous diverging sprays of needle-like (acicular) crystals. The unique sky-blue color is a result of copper inclusions, creating a unique, natural and beautiful color. In excellent condition. Location: Yunan Province, China Size: 13.5 x 7.8 x...- $290.00
- $290.00
- Unit price
- per
Mixed Minerals 1

- Choosing a selection results in a full page refresh.